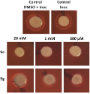

Search results
Search for "Quorum sensing" in Full Text gives 27 result(s) in Beilstein Journal of Organic Chemistry.
Origami with small molecules: exploiting the C–F bond as a conformational tool
Beilstein J. Org. Chem. 2025, 21, 680–716, doi:10.3762/bjoc.21.54

Photoswitchable glycoligands targeting Pseudomonas aeruginosa LecA
Beilstein J. Org. Chem. 2024, 20, 1486–1496, doi:10.3762/bjoc.20.132
- increasingly limited for treatment of infections. PA has been classified as a priority 1 pathogen by the WHO [2][3]. Various approaches to treating PA, in addition to traditional antibiotics, have been developed including inhibition of quorum sensing, biofilm formation, iron chelation, and interfering with
A Diels–Alder probe for discovery of natural products containing furan moieties
Beilstein J. Org. Chem. 2024, 20, 1001–1010, doi:10.3762/bjoc.20.88

- the titers of MMFs in native producing strains. However, if titers are similar to that of γ-butyrolactones and butenolides quorum sensing molecules, we would expect them to be between 80 and 2.5 nM [29][30][31]. Given these very low concentrations, cultures would need to be greatly concentrated (≈1000
Synthetic approach to 2-alkyl-4-quinolones and 2-alkyl-4-quinolone-3-carboxamides based on common β-keto amide precursors
Beilstein J. Org. Chem. 2023, 19, 1804–1810, doi:10.3762/bjoc.19.132
- great research interest, with many reviews published in the recent years [20][21][22]. Some of the compounds are known to act as antibiotics [23][24][25][26], while others function as quorum-sensing signal molecules which regulate the production and release of virulence factors in bacteria, thus helping
- conditions, and allows easy installation of long-chain substituents at the C-2 position of the quinolone core. These characteristics of the synthetic method could be particularly attractive in the search of novel mimics of the Pseudomonas quorum-sensing signal molecules. The high activity of compounds 4d and
- natural products of microbial origin such as HHQ and its C5-congener. Two compounds with high activity against S. aureus have been identified among the newly obtained quinolones, with MICs ≤ 3.12 and ≤ 6.25 µg/mL, respectively. Keywords: antibacterial; β-keto amides; enaminones; 4-quinolones; quorum
Intermediates and shunt products of massiliachelin biosynthesis in Massilia sp. NR 4-1
Beilstein J. Org. Chem. 2023, 19, 909–917, doi:10.3762/bjoc.19.69
- ]. Natural products that are structurally related to 1–6 were discovered in Pseudomonas aeruginosa. It was shown that these compounds function as signaling molecules involved in quorum sensing and stress response [24] which might be an explanation for their low bioactivity against the tested bacteria. Upon
Using UHPLC–MS profiling for the discovery of new sponge-derived metabolites and anthelmintic screening of the NatureBank bromotyrosine library
Beilstein J. Org. Chem. 2022, 18, 1544–1552, doi:10.3762/bjoc.18.164
- the purealidin bromotyrosine structure class, however, quorum sensing inhibition and antifouling activities against several strains of bacteria and microalgae appears in the literature [33][34], while HIV-1 replication inhibition and anti-Leishmania and Plasmodium activity has also been recorded [35
4-Hydroxy-3-methyl-2(1H)-quinolone, originally discovered from a Brassicaceae plant, produced by a soil bacterium of the genus Burkholderia sp.: determination of a preferred tautomer and antioxidant activity
Beilstein J. Org. Chem. 2020, 16, 1489–1494, doi:10.3762/bjoc.16.124
- rutaceous plants [9]. Examples from microbes include chymase inhibitors SF2809-I to VI from an actinomycete of the genus Dactylosporangium [10], a quorum sensing signaling molecule 2,4-dihydroxyquinoline (DHQ, 4) from Gram-negative bacteria Pseudomonas aeruginosa and Burkholderia thailandensis, [7], and 4-O
Synthesis of novel sulfide-based cyclic peptidomimetic analogues to solonamides
Beilstein J. Org. Chem. 2019, 15, 2544–2551, doi:10.3762/bjoc.15.247
- analogues were prepared in moderate overall yields and did not show toxic effects on Staphylococcus aureus growth and were not toxic to human fibroblasts. Two of them inhibited the hemolytic activity of S. aureus, suggesting an interfering action in the bacterial quorum sensing similar to the one already
- , methicillin-resistant S. aureus (MRSA) is considered an endemic cause of nosocomial infections and has spread into the community and livestock animals as well [8]. Expression of many S. aureus virulence factors is controlled by a sophisticated intercellular chemical signalling pathway named quorum-sensing (QS
- exert an effect on S. aureus quorum sensing. To evaluate this hypothesis, we are now rationally designing new solonamide analogues, based on the SN2’ strategy reported here, to be tested for AgrC-inhibitory activity. Chemical structure of solonamides and autoinducing peptides (AIP). Effect of compounds
Synthesis and biological activity of methylated derivatives of the Pseudomonas metabolites HHQ, HQNO and PQS
Beilstein J. Org. Chem. 2019, 15, 187–193, doi:10.3762/bjoc.15.18
- are associated with quorum sensing and virulence of the human pathogen Pseudomonas aeruginosa, have been prepared. While the synthesis by direct methylation was successful for 3-unsubstituted 2-heptyl-4(1H)-quinolones, methylated derivatives of the Pseudomonas quinolone signal (PQS) were synthesized
- from 3-iodinated quinolones by methylation and iodine–metal exchange/oxidation. The two N- and O-methylated derivatives of the PQS showed strong quorum sensing activity comparable to that of PQS itself. Staphylococcus aureus, another pathogenic bacterium often co-occurring with P. aeruginosa especially
- in the lung of cystic fibrosis patients, was inhibited in planktonic growth and cellular respiration by the 4-O-methylated derivatives of HQNO and HHQ, respectively. Keywords: antibiotic acitivity; methylation; Pseudomonas aeruginosa; quinolones; quorum sensing; Introduction 2-Alkyl-4(1H
N-Acylated amino acid methyl esters from marine Roseobacter group bacteria
Beilstein J. Org. Chem. 2018, 14, 2964–2973, doi:10.3762/bjoc.14.276
- Roseobacter group (Rhodobacteraceae) are important members of many marine ecosystems. Similar to other Gram-negative bacteria many roseobacters produce N-acylhomoserine lactones (AHLs) for communication by quorum sensing systems. AHLs regulate different traits like cell differentiation or antibiotic
- derivatives; 2-aminobutyric acid; homoserine lactones; natural products; quorum sensing; Introduction The identification and structural elucidation of naturally occurring compounds traditionally requires isolation and NMR investigation as key method to detect novel compounds and new structural classes
- habitats with a broad metabolic potential [4][5][6][7]. Especially attached-living roseobacters produce diverse secondary metabolites, e.g., N-acylhomoserine lactones (AHLs) that the bacteria use for communication by quorum sensing [8][9][10]. AHLs are extensively investigated because of the broad
Synthesis of pyrrolidine-based hamamelitannin analogues as quorum sensing inhibitors in Staphylococcus aureus
Beilstein J. Org. Chem. 2018, 14, 2822–2828, doi:10.3762/bjoc.14.260
- product hamamelitannin and several of its analogues have been identified as quorum sensing inhibitors. In this paper the synthesis of pyrrolidine-based analogues of a more lead-like hamamelitannin analogue is reported. A convergent synthetic route based on a key ring-closing metathesis reaction was
- ; quorum sensing; Staphylococcus aureus; Introduction Antimicrobial resistance is rapidly becoming a global threat [1][2]. It is estimated that worldwide, at least 700 000 people die every year from drug-resistant strains of common bacterial infections. Strategies to deal with the global antimicrobial
- clinical infections. In S. aureus, virulence is mainly mediated by quorum sensing, a bacterial cell-to-cell communication system based on the secretion of signal molecules [9][10][11]. The natural product hamamelitannin (1) has been identified as a non-peptide analogue of RIP (RNAIII-inhibiting protein
Synthesis and biological evaluation of 1,2-disubstituted 4-quinolone analogues of Pseudonocardia sp. natural products
Beilstein J. Org. Chem. 2018, 14, 2680–2688, doi:10.3762/bjoc.14.245
- analogues was observed to inhibit production of the virulence factor pyocyanin in the human pathogen Pseudomonas aeruginosa, which may be a result of their similarity to the Pseudomonas quinolone signal (PQS) quorum sensing autoinducer. This provided new insights regarding the effect of N-substitution in
- PQS analogues, which has been hitherto underexplored. Keywords: antibiotics; cross-coupling; heterocycles; quorum-sensing; structure–activity relationships; Introduction The quinolone core has long been implemented in structures possessing formidable activity in a broad range of fields, including
- -position, there is a structural resemblance to the Pseudomonas quinolone signal (PQS), and its biosynthetic precursor 2-heptyl-4(1H)-quinolone (HHQ), which are vital to the cooperative behaviour of the human pathogen Pseudomonas aeruginosa via quorum sensing (QS). This is a means by which bacteria alter
Non-native autoinducer analogs capable of modulating the SdiA quorum sensing receptor in Salmonella enterica serovar Typhimurium
Beilstein J. Org. Chem. 2018, 14, 2651–2664, doi:10.3762/bjoc.14.243

- Matthew J. Styles Helen E. Blackwell Department of Chemistry, University of Wisconsin–Madison, 1101 University Avenue, Madison, WI 53706, USA 10.3762/bjoc.14.243 Abstract Quorum sensing (QS) allows many common bacterial pathogens to coordinate group behaviors such as virulence factor production
- and antagonism. Keywords: N-acyl L-homoserine lactone; LuxR-type receptor; Quorum sensing; Salmonella enterica serovar Typhimurium; SdiA; Introduction In the fight against bacterial infections, microbes have a decisive advantage over the medical community: evolution [1]. Using bacteriocidal or
- to complement antibiotics, and the interception of quorum sensing (QS) in bacteria has attracted considerable attention in this regard [7][8][9]. QS, a type of intra- and interspecies chemical communication, has been found to occur in many common bacterial pathogens [10][11]. These pathogens use QS
Targeting the Pseudomonas quinolone signal quorum sensing system for the discovery of novel anti-infective pathoblockers
Beilstein J. Org. Chem. 2018, 14, 2627–2645, doi:10.3762/bjoc.14.241

- , 66123 Saarbrücken, Germany German Centre for Infection Research (DZIF), Partner Site Hannover-Braunschweig, Saarbrücken, Germany 10.3762/bjoc.14.241 Abstract The Gram-negative opportunistic pathogen Pseudomonas aeruginosa causes severe nosocomial infections. It uses quorum sensing (QS) to regulate and
- highlights the published drug discovery efforts providing insights into the compound binding modes if available. Furthermore, suitability of the individual targets for pathoblocker design is discussed. Keywords: anti-infectives; pathoblockers; PQS; Pseudomonas aeruginosa; quorum sensing; Introduction In
- disruption of the Pseudomonas quinolone signal quorum sensing system (pqs QS). Review Antimicrobial resistance and clinical relevance of Pseudomonas aeruginosa P. aeruginosa is one of the threatening ESKAPE pathogens and has regularly been attributed with the label ‘superbug’ [11]. In 2017, the World Health
Pathoblockers or antivirulence drugs as a new option for the treatment of bacterial infections
Beilstein J. Org. Chem. 2018, 14, 2607–2617, doi:10.3762/bjoc.14.239
- . Keywords: antimicrobial resistance; bacterial adhesins; bacterial toxins; pathoblockers; quorum sensing; Review 1. Antimicrobial resistance crisis for bacterial infections The current crisis caused by antimicrobial resistance [1][2] demands new strategies to fight infections. Antibiotics have served as
- a suitable target to prevent toxin secretion. The anti-PcrV antibody KB001 [68] and the bifunctional antibody MEDI3902 [69], which targets PcrV and the biofilm-associated exopolysaccharide psl, are both currently in phase II clinical trials. 6. Bacterial communication Quorum sensing (QS) is employed
- that activates quorum sensing-controlled processes (Figure 5). Many virulence traits are influenced by quorum sensing and thus developing methods to reduce virulence by interfering with bacterial communication is currently a topic of intense research efforts. Quorum sensing exists in Gram-negative and
Impact of Pseudomonas aeruginosa quorum sensing signaling molecules on adhesion and inflammatory markers in endothelial cells
Beilstein J. Org. Chem. 2018, 14, 2580–2588, doi:10.3762/bjoc.14.235

- of Agronomical Sciences and Veterinary Medicine, Faculty of Veterinary Medicine, Bucharest, Romania Institute of Cellular Biology and Pathology Nicolae Simionescu of Romanian Academy, Romania 10.3762/bjoc.14.235 Abstract Pseudomonas aeruginosa relies on the quorum sensing (QS) signaling system as a
- develop anti-QS therapeutic strategies to fight against P. aeruginosa infections. Keywords: adhesion; host–pathogen interaction; inflammation; Pseudomonas; quorum sensing; Introduction Pseudomonas (P.) aeruginosa is an opportunistic pathogen that causes severe and persistent infections in immune
- compromised individuals and in patients with bronchiectasis or cystic fibrosis. The infections become chronic, as P. aeruginosa develops resistance to conventional antibiotics due to its ability to produce virulence factors and modulate immune defenses by quorum sensing (QS) and biofilm production
Defining the hydrophobic interactions that drive competence stimulating peptide (CSP)-ComD binding in Streptococcus pneumoniae
Beilstein J. Org. Chem. 2018, 14, 1769–1777, doi:10.3762/bjoc.14.151

- States 10.3762/bjoc.14.151 Abstract Quorum sensing (QS) is a cell–cell communication mechanism that enables bacteria to assess their population density and alter their behavior upon reaching high cell number. Many bacterial pathogens utilize QS to initiate an attack on their host, thus QS has attracted
- stimulating peptide (CSP); protein–peptide interactions; quorum sensing; Streptococcus pneumoniae; structure–activity relationships (SAR); Introduction Quorum sensing (QS), a cell-density mechanism utilized by bacteria to assess their population density through the detection of diffusible signal molecules
Acyl-group specificity of AHL synthases involved in quorum-sensing in Roseobacter group bacteria
Beilstein J. Org. Chem. 2018, 14, 1309–1316, doi:10.3762/bjoc.14.112
- /bjoc.14.112 Abstract N-Acylhomoserine lactones (AHLs) are important bacterial messengers, mediating different bacterial traits by quorum sensing in a cell-density dependent manner. AHLs are also produced by many bacteria of the marine Roseobacter group, which constitutes a large group within the marine
- ; fatty acid composition; N-acylhomoserine lactones; quorum sensing; Phaeobacter inhibens; Introduction The Roseobacter group, a subgroup of the Rhodobacteraceae family, constitutes an important class of Gram-negative marine bacteria, occurring in many different habitats [1][2], in fresh water as well as
- on surfaces [3]. They can produce a variety of secondary metabolites, including antibiotics [4][5], volatile compounds [6][7], oligohydroxybutyrates [8] and a range of N-acylhomoserine lactones (AHLs) [8][9][10]. AHLs are quorum-sensing signaling compounds that are used for cell–cell communication to
Posttranslational isoprenylation of tryptophan in bacteria
Beilstein J. Org. Chem. 2017, 13, 338–346, doi:10.3762/bjoc.13.37
- the thiol groups of proteins in eukaryotes. In contrast, the Bacillus quorum sensing peptide pheromone, the ComX pheromone, possesses a posttranslationally modified tryptophan residue, and the tryptophan residue is isoprenylated with either a geranyl or farnesyl group at the gamma position to form a
- ; isoprenylation; post-translational modification; quorum sensing; tryptophan; Introduction Posttranslational modification is the chemical modification of proteins after their translation from mRNAs to the corresponding polypeptide chains synthesized by ribosomes. Since a posttranslational modification generates
- tryptophan residue of the quorum sensing pheromone from Bacillus subtilis, the ComX pheromone [13]. Quorum sensing is a specific gene expression system dependent on the cell density [14]. In terms of a competition for survival, the cell population density is one of the largest factors for microorganisms
Chemical probes for competitive profiling of the quorum sensing signal synthase PqsD of Pseudomonas aeruginosa
Beilstein J. Org. Chem. 2016, 12, 2784–2792, doi:10.3762/bjoc.12.277

- Michaela Prothiwa David Szamosvari Sandra Glasmacher Thomas Bottcher Department of Chemistry, Konstanz Research School Chemical Biology, University of Konstanz, 78457 Konstanz, Germany 10.3762/bjoc.12.277 Abstract The human pathogen Pseudomonas aeruginosa uses the pqs quorum sensing system to
- coordinate the production of its broad spectrum of virulence factors to facilitate colonization and infection of its host. Hereby, the enzyme PqsD is a virulence related quorum sensing signal synthase that catalyzes the central step in the biosynthesis of the Pseudomonas quinolone signals HHQ and PQS. We
- is coordinated on population level by several layers of hierarchically interconnected quorum sensing systems [6]. Quorum sensing signals are released from the cells and accumulate in a growing bacterial population to a certain threshold by which they start inducing the production of virulence factors
Discovery of an inhibitor of the production of the Pseudomonas aeruginosa virulence factor pyocyanin in wild-type cells
Beilstein J. Org. Chem. 2016, 12, 1428–1433, doi:10.3762/bjoc.12.137
- . aeruginosa infections. Evidence suggests that the active compound reduces the level of pyocyanin production by inhibiting the cell–cell signalling mechanism known as quorum sensing. This could have interesting implications; quorum sensing regulates a range of additional elements associated with the
- pathogenicity of P. aeruginosa and there is a wide range of other potential applications where the inhibition of quorum sensing is desirable. Keywords: antibacterial; antivirulence; Pseudomonas aeruginosa; pyocyanin; quorum sensing; Findings The Gram-negative bacterium Pseudomonas aeruginosa is a clinically
- inhibition of this phenotype by a member of this structural sub-class. Thus, a promising new scaffold for pyocyanin inhibition has been identified. A cell–cell signalling process known as quorum sensing regulates pyocyanin production by P. aeruginosa [8][9][20]. This bacterium uses (at least) three different
Cyclisation mechanisms in the biosynthesis of ribosomally synthesised and post-translationally modified peptides
Beilstein J. Org. Chem. 2016, 12, 1250–1268, doi:10.3762/bjoc.12.120

- thiolactone is generated in AIP biosynthesis (Figure 9). Autoinducing peptides are secreted molecules that form part of a quorum-sensing system in Staphylococcus [121]. Heterologous expression in E. coli showed that only AgrD (precursor peptide) and AgrB (peptidase) are required for AIP biosynthesis, although
- candidate enzymes. A number of these cyclisations are found in partially characterised pathways, such as the S–C cross-link in α-amanitin (Figure 8B) that is formed between cysteine and tryptophan residues (the tryptathionine linkage [131]). The ComQXPA quorum sensing (QS) system [132] found in Bacillus
A novel and widespread class of ketosynthase is responsible for the head-to-head condensation of two acyl moieties in bacterial pyrone biosynthesis
Beilstein J. Org. Chem. 2015, 11, 1412–1417, doi:10.3762/bjoc.11.152
- , 60438 Frankfurt am Main, Germany 10.3762/bjoc.11.152 Abstract The biosynthesis of photopyrones, novel quorum sensing signals in Photorhabdus, has been studied by heterologous expression of the photopyrone synthase PpyS catalyzing the head-to-head condensation of two acyl moieties. The biochemical
- including a novel derivative. Moreover this novel class of ketosynthases is only distantly related to other pyrone-forming enzymes identified in the biosynthesis of the potent antibiotics myxopyronin and corallopyronin. Keywords: cell–cell communication; ketosynthase; photopyrones; pseudopyronines; quorum
- sensing; Introduction Chemical compounds containing an α-pyrone moiety are widespread in nature [1][2] and show a high diversity in their biological activity. Members of this class of compounds have been identified with antimicrobial, cytotoxic [3] and antitumor activities [4], as HIV protease inhibitors
Synthesis and biological evaluation of novel N-α-haloacylated homoserine lactones as quorum sensing modulators
Beilstein J. Org. Chem. 2014, 10, 2539–2549, doi:10.3762/bjoc.10.265
- atom was introduced at the α-position of the carbonyl function of the N-acyl chain, have been studied as quorum sensing (QS) modulators and compared with a library of natural N-acylated homoserine lactones (AHLs). The series of novel analogues consists of α-chloro, α-bromo and α-iodo AHL analogues
- ; N-α-haloacylated homoserine lactones; quorum sensing; Introduction Quorum sensing (QS) is the communication system used by bacteria allowing them to adapt to their environment [1]. Bacteria relying on QS secrete signal molecules, called autoinducers, in order to control the expression of specific
- target genes important for phenotype expression (e.g., biofilm formation, bioluminescence, virulence expression, etc.) in a population density dependent manner [2]. The importance of QS for virulence development in pathogenic bacteria nowadays is obvious [3]. Therefore, quorum sensing modulation is seen
Activation of cryptic metabolite production through gene disruption: Dimethyl furan-2,4-dicarboxylate produced by Streptomyces sahachiroi
Beilstein J. Org. Chem. 2013, 9, 1768–1773, doi:10.3762/bjoc.9.205
- organisms remain “silent” within the genome [1][2]. While the biosynthetic machinery appears functional, the genetic loci are frequently (but not always) unexpressed. The activation of such pathways has garnered interest from the scientific community. Quorum sensing refers to the process by which